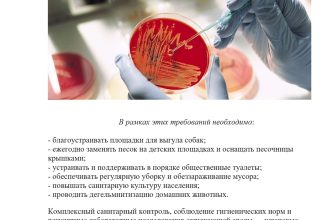

Кино – это искусство, способное передать истории и эмоции нашими собственными языками. Кино также является средством, которое позволяет нам увидеть и восхититься прекрасными вещами, которые встречаются нам в жизни. Один из таких удивительных предметов – велосипед.
Велосипед играл важную роль в истории кино. От беспечных прогулок по городским улицам до динамичных гонок и повседневных поездок, велосипед всегда был неотъемлемой частью различных фильмов. Он становится символом свободы, приключений и детства.
Во многих фильмах велосипед играет знаковую роль и помогает раскрыть характеры героев. Иногда велосипеды становятся центром внимания, а иногда они служат всего лишь вспомогательным атрибутом, добавляющим уникальность в сцене. Независимо от роли, которую они играют, велосипеды неизменно привлекают внимание зрителя и добавляют особое очарование и динамику в фильмы.
- Как велосипеды стали знаковыми аксессуарами героев кино?
- Велосипеды — символ свободы
- Велосипеды — подчеркивание характера героев
- Велосипеды и известные фильмы: топ-5 знаковых моментов
- 1. Велосипедный иронический погоня в фильме «Езда по облакам» (1942)
- 2. Велосипед и детство в фильме «ЭТ» (2017)
- 3. Велотакси в фильме «Амели» (2001)
- 4. Гонка на велосипедах в фильме «Перевозчик» (2002)
- 5. Семейная поездка на велосипеде в фильме «Возвращение домой» (2015)
- Велосипеды в сценах погонь и экшна: как две колеса создают эффект скорости
- Велосипеды как символ свободы и молодости: почему эти атрибуты притягивают киноиндустрию?
- Вопрос-ответ:
- Какие фильмы стали символом велосипедной культуры в кино?
- В каких сценах известных фильмов использовались велосипеды?
- Какие эмоции передает использование велосипеда в кино?
- Как велосипеды влияют на характер героев в фильмах?
- Есть ли велосипедные фильмы, снятые в России?
- Какие фильмы включают в себя сцены с велосипедами?
- Как велосипеды используются в кино для передачи определенных эмоций или символизма?
- Видео:
- Какой велосипед быстрее в городе? #RADShow 2
Как велосипеды стали знаковыми аксессуарами героев кино?
Велосипеды давно стали неотъемлемой частью мирового кинематографа. Они стали символом свободы, приключений и молодости. Велосипеды в кино используются для создания реалистичных сцен, передачи настроения и подчеркивания характера героев.
Велосипеды — символ свободы
Когда мы видим героя на велосипеде, мы сразу ассоциируем его с свободой. Велосипед дает возможность передвигаться без препятствий и ощущать полную независимость. Это особенно хорошо видно в фильмах о подростках, где велосипеды становятся своего рода «крыльями» для главных героев. Они позволяют им исследовать мир, взрослеть и находить свое место в жизни.
Велосипеды — подчеркивание характера героев
Кроме того, велосипеды помогают создать образ героя и подчеркнуть его характеристики. К примеру, герой на скоростном гоночном велосипеде может быть агрессивным и соревновательным, а герой на старом велосипеде — мечтательным и романтичным. Велосипеды создают некую метафору или символическое отражение личности героя.
![]() | ![]() |
| Велосипед 1 | Велосипед 2 |
Таким образом, велосипеды стали неотъемлемой частью кино и играют важную роль в создании образов героев и передаче настроения. Они помогают нам окунуться в сюжет и погрузиться в мир кино, а также вдохновляют на приключения и свободу.
Велосипеды и известные фильмы: топ-5 знаковых моментов

В фильмах велосипеды не только выполняют функцию транспортного средства, но часто становятся символом свободы, приключений и романтики. Они помогают создать атмосферу и передать эмоции героев. Ниже представлены пять знаковых моментов, связанных с велосипедами, известных фильмов:
1. Велосипедный иронический погоня в фильме «Езда по облакам» (1942)

В этой классической романтической комедии главные герои бегут от преследования на велосипедах. Их погоня становится символом борьбы за свободу и возможностью выбора. Комбинированная игра актеров и динамичные съемки делают эту сцену незабываемой.
2. Велосипед и детство в фильме «ЭТ» (2017)

В этом фильме-ужасе много моментов, связанных с велосипедом, но особенно запоминается сцена, где группа детей едет на своих велосипедах по городу в поисках приключений. Велосипеды становятся символом дружбы, смелости и невинности детства.
3. Велотакси в фильме «Амели» (2001)
Французский фильм «Амели» стал настоящей культовой работой. В нем главная героиня Амели Пулен использует велосипед в качестве такси, чтобы помочь влюбленным. Такая необычная и романтичная атмосфера создается благодаря велосипеду, который становится символом нежности и доброты.
4. Гонка на велосипедах в фильме «Перевозчик» (2002)
В фильме «Перевозчик» Джейсон Стэтем снимает соперников за гонкой на велосипедах. Эта сцена ярко демонстрирует его физическую подготовку и навыки. Здесь велосипед становится символом скорости, ловкости и вызова.
5. Семейная поездка на велосипеде в фильме «Возвращение домой» (2015)
В фильме «Возвращение домой» Вигго Мортенсен играет отца троих детей, который решает сделать семейную поездку на велосипеде через всю Америку. Эта опасная и захватывающая поездка становится символом смелости, приключений и семейной любви.
Это только некоторые из множества примеров знаковых моментов с велосипедами в фильмах. Внесение велосипеда в сюжет обогащает кинематографическую работу, подчеркивая идеи и эмоции героев.
Велосипеды в сценах погонь и экшна: как две колеса создают эффект скорости
Когда персонажи в кино садятся на велосипеды, кадры сразу наполняются движением. Скоростные съемки, перемещающиеся по улицам города или лесным тропам, делают зрителей активными участниками действия. В моменты погони на велосипедах, зрители могут почувствовать адреналин и вовлеченность в происходящее.
Важными элементами сцен погонь на велосипедах являются верность деталей и хорошая физическая подготовка актеров. Даже если сцена снимается на зеленом экране, актеры должны продемонстрировать уверенность и ловкость в управлении велосипедом.
Камеры, установленные на велосипедах или прикрепленные к актерам, позволяют создать дополнительный эффект скорости и динамики. Благодаря этим специальным устройствам кинематографисты могут подчеркнуть скорость движения и передать ощущение быстроты.
Еще одним важным аспектом сцен погонь на велосипедах является соответствующая музыкальная подложка. Динамичная музыка, соответствующая действию, помогает создать эффект напряжения и ускорения. В сочетании с кадрами, передающими скорость и движение, музыка помогает зрителям почувствовать энергию и адреналин.
Итак, велосипеды в сценах погонь и экшна – это не просто средство передвижения для персонажей, это способ создать ускорение и динамику в фильме. Сочетание скоростных съемок, физической подготовки актеров, специальных камер и эффектной музыки делает такие сцены незабываемыми и захватывающими.
Велосипеды как символ свободы и молодости: почему эти атрибуты притягивают киноиндустрию?

Велосипеды в кино не просто средство передвижения, а мощный символ: свободы, молодости и независимости. Они вызывают ассоциации с беззаботным детством, приключениями и непокорной энергией.
Первые велосипеды появились в XIX веке, и с тех пор эти двухколесные транспортные средства стали неотъемлемой частью нашей культуры. Они быстро стали популярными среди молодежи и символизировали стремление к свободе и независимости.
В фильмах велосипеды активно использовались в сценах, где нужно передать дух свободы и преследования. Благодаря легкой маневренности велосипедов, режиссеры могут создавать захватывающие и динамичные сцены преследований и погонь.
В киноиндустрии велосипеды часто ассоциируются с персонажами, которые отличаются молодостью, энергией и стремлением к приключениям. Они становятся символом бесконечной свободы и возможностей, отражающим желание героев освободиться от привязанностей и табу общества. Этот символ также акцентирует важность сохранения молодости духа и страсти к жизни.
Велосипеды в кино могут также быть знаками презрения к авторитетам и стереотипам. Герои, выбирающие велосипеды вместо привычных автомобилей, показывают свою непредсказуемость и независимость. Они отказываются подчиняться общественным нормам и предпочитают самостоятельное передвижение на двух колесах.
Велосипеды в кино также способны передать атмосферу счастья и независимости. Сцены, где герои ездят на велосипедах, зачастую наполняются яркой солнечной погодой и легкостью вида. Эти моменты передают чувство легкости, радости и свободы.
Вопрос-ответ:
Какие фильмы стали символом велосипедной культуры в кино?
Среди таких фильмов можно выделить культовую картину «Велосипедисты» режиссера Витторио Де Сика и американский приключенческий фильм «Е.Т. и пришелец» Стивена Спилберга.
В каких сценах известных фильмов использовались велосипеды?
Велосипеды использовались в различных сценах фильмов, например, в сценах преследования, в сценах романтических прогулок или просто в качестве средства передвижения героев.
Какие эмоции передает использование велосипеда в кино?
Велосипед в кино может символизировать свободу, приключения, беззаботность или даже романтику. Он может передавать энергию и движение, создавая динамичные и захватывающие сцены.
Как велосипеды влияют на характер героев в фильмах?
Велосипеды могут влиять на характер героев в фильмах, в зависимости от контекста. Например, использование велосипеда может указывать на активный и созидательный характер героя, его физическую подготовку или просто на его любовь к природе и активному образу жизни.
Есть ли велосипедные фильмы, снятые в России?
Да, в России также были сняты фильмы, где велосипеды играют важную роль. Например, такие картины, как «Кин-дза-дза!» или «Любовь и голуби» с известным советским актером Алексеем Баталовым.
Какие фильмы включают в себя сцены с велосипедами?
В фильмах можно увидеть сцены с велосипедами в разных жанрах: от драмы до комедии. Некоторые из них включают такие известные фильмы, как «ЭТ» (2017), «Единственное, что я хочу» (2019), «Исчезновение» (2012), «Большие надежды» (2012) и многие другие.
Как велосипеды используются в кино для передачи определенных эмоций или символизма?
Велосипеды в кино могут использоваться для передачи различных эмоций или символизма. Например, велосипед может служить символом свободы и независимости, особенно в фильмах о подростках. Он также может использоваться для передачи ощущения приключений или романтики. Сцены с велосипедами могут быть эмоционально насыщенными и использоваться для передачи счастья, радости или горя.